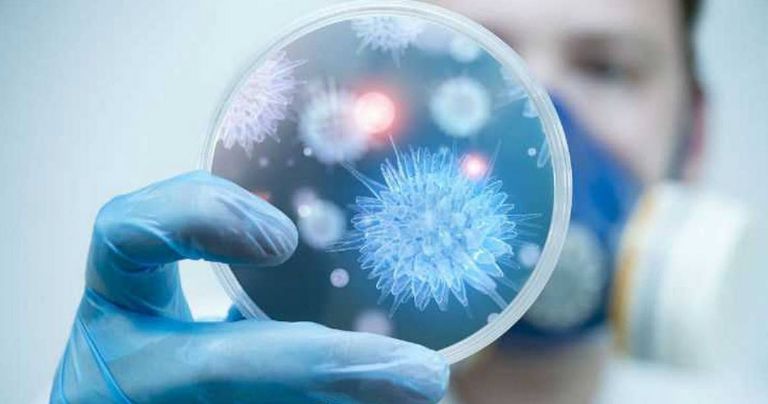

Ciudad de México.- En los últimos meses, la preocupación por el Covid-19 ha aumentado gracias a la aparición de nuevas variantes en países como Brasil, Reino Unido y Sudáfrica, las cuales son mucho más agresivas de lo que hasta ahora se conoce del virus, pero sorprendentemente una de estas cepas podría ser la protección de las otras.
Se trata de la mutación conocida como 501Y.V2, descubierta en el país africano, la cual, de acuerdo con estudios realizados por las autoridades de salud de la entidad, genera anticuerpos que pueden proteger también de las variantes que surgen en otros lugares del mundo.
Te puede interesar: Expertos de EU alertan sobre un nuevo efecto secundario de la vacuna de Moderna

Para los expertos esto es una buena noticia ya que permite pensar en la posibilidad de una vacuna hecha especialmente para la cepa sudafricana con la que podría ofrecer la inmunidad cruzada frente al coronavirus.
El plasma recogido de personas infectadas con 501Y.V2 tiene buena actividad neutralizante contra la propia variante y también contra los virus de la primera ola y potencialmente contra otras variantes de preocupación'', aseguraron los expertos durante un seminario virtual organizado por el Gobierno de Sudáfrica.
Te puede interesar: Esto es lo que podría pasar si se baja la guardia ante el coronavirus, según la OMS
Hasta el momento los anticuerpos generados naturalmente han dado buenos resultados contra la mutación de Brasil, por lo que una inyección basada en este proceso podría significar para los expertos, el fin de la pandemia, ya que se deja sin posibilidad de acción al virus.
En este sentido, las autoridades de salud enfatizan que los laboratorios que han creado las vacunas que lideran las jornadas de vacunación en todo el mundo, es decir, Moderna, Pfizer, AstraZeneca y Johnson & Johnson, ya se encuentran trabajando en una vacuna para la variante sudafricana.
Fuente: El universal









